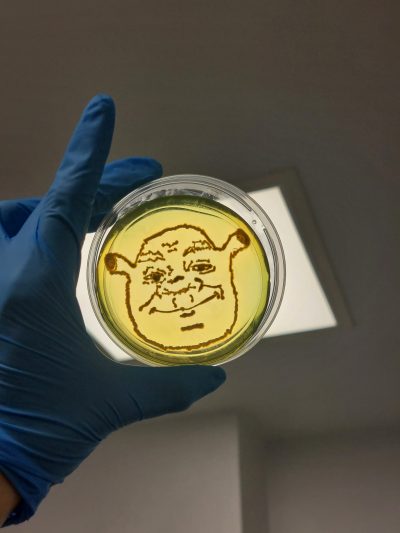
6-Shrek

Shrek is love, Shrek is science
Publicada el 9/03/2026
Título: Shrek is love, Shrek is science
Autor: Laura Álvaro Llorente
Instituto Ramón y Cajal de Investigación Sanitaria. Ctra. de Colmenar Viejo, Km. 9,100. 28034 Madrid
Descripción: En el mundo de las bacterias, E. coli puede parecer un ogro temible en una placa Petri, pero, en muchas ocasiones, es el guardián de la ciénaga, manteniendo a raya a los patógenos del intestino.